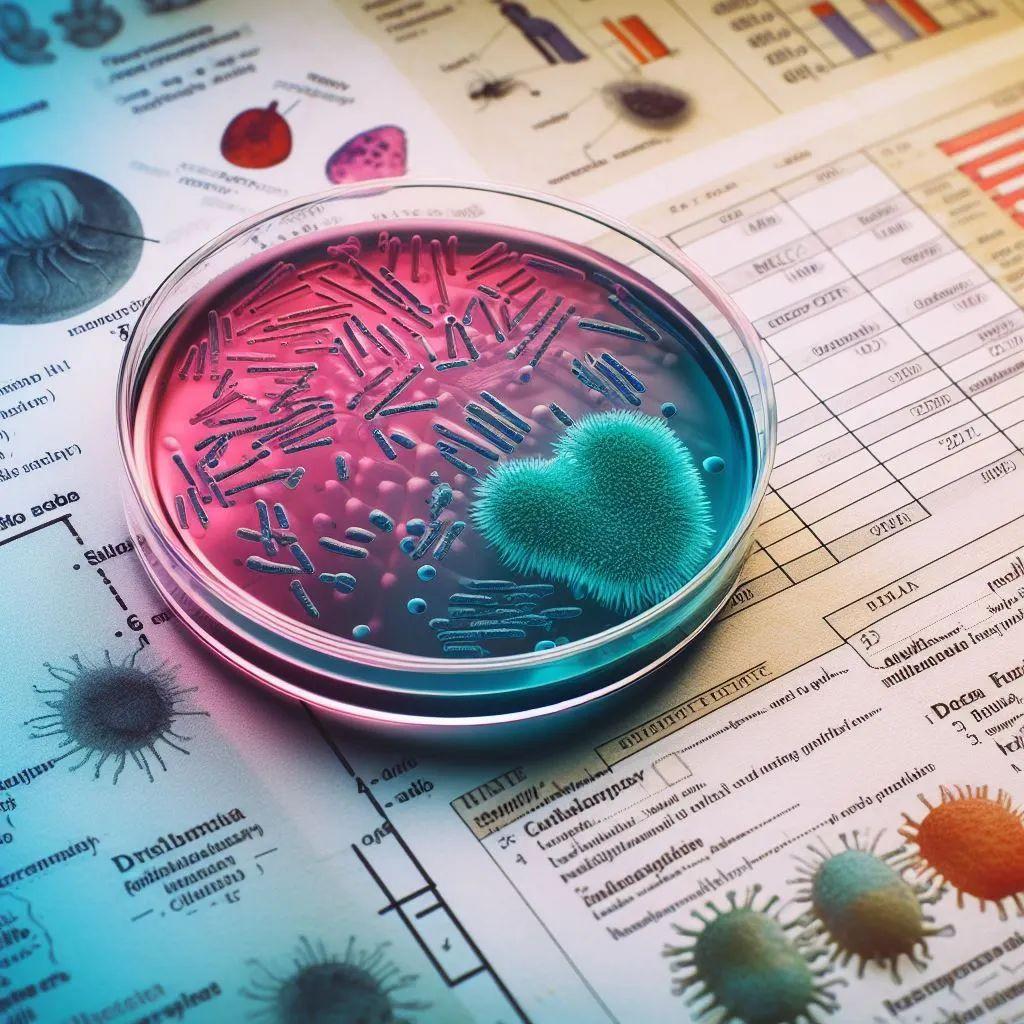
菌株生长的背后黑手 知乎

好熱菌(こうねつきん)は、至適生育温度が45°C以上、あるいは生育限界温度が55°C以上の微生物のこと、またはその総称。古細菌の多く、細菌の一部、ある種の菌類や藻類が含まれる。特に至適生育温度が80°C以上のものを超好熱菌と呼ぶ。極限環境微生物の一つ。
生息域は温泉や熱水域、強く発酵した堆肥、熱水噴出孔など。ボイラーなどの人工的熱水からも分離される。この他、地下生物圏という形で地殻内に相当量の好熱菌が存在するという推計がある。
なお、2009年時点で最も好熱性が強い(高温環境を好む)生物は、ユーリ古細菌に含まれるMethanopyrus kandleri Strain 116である。この生物はオートクレーブ温度を上回る122°Cでも増殖することができる。
ストレス耐性機構
よく研究されている好熱菌のストレス耐性には、高温に対するものと低温に対するものの二つがある。微生物にとって、温度ストレスの耐性機構にて求められることは高塩濃度、強酸性、強塩基性などのそれとは異なる。塩、あるいは酸、塩基の高濃度環境に対しては、細胞内濃度を生物にとって適切なものに維持することで適応できる。すなわち、細胞内に取り込まないようにする、かつ、細胞外に効率的に排出する機構を備えることが要求される。対して、恒温能力を備えない微生物にとって温度は細胞内外で変化させることができない。したがって、微生物の温度ストレスで求められることは、細胞内生理現象をその温度で適切に運営することである。
高温耐性
好熱菌の至適生育温度は80℃以上であるが、この温度の高さが引き起こす生化学的な問題として以下が知られている。①タンパク質が変成する。②核酸(DNAとRNA)の二本鎖も変成して解離しやすくなる。③真核生物や細菌の膜脂質のように、炭化水素部分とグリセロール部分との間の結合がエステル結合の場合、切断されやすい。④一部の代謝中間体は熱により分解されやすい。
また、好熱菌の生息する自然環境(熱水噴出孔や陸上温泉)の温度は至適生育温度以上に上昇することもありうる。このため、超好熱菌であっても熱ショック応答の機構を有している。この応答機構は転写因子により誘導される。
タンパク質の変成については、好熱菌はイオン結合を増やすことでこれを抑制している。イオン結合を形成するアミノ酸(Arg, Glu, Val)のタンパク質中での割合が好熱菌では高く、逆にAsn, Asp, Cys, Gln, Serの割合は低い。典型的な例はO6-メチルグアニン-DNAメチル転移酵素(MGMT)である。超高熱菌であるThermococcus kodakarensisのMGMT(Tk-MGMT)と、大腸菌由来のMGMT相当タンパク質(適応応答制御タンパク質のC末端側ドメイン:AdaC)を比較すると、前者の表面で荷電性アミノ酸残基のイオン結合がより多く存在することがわかる。また、Tk-MGMTでα-ヘリックス内および2つのα-ヘリックス間においてもより多い。さらに、AdaCと比べてTk-MGMTは分子内部により多くの芳香族アミノ酸を含み、疎水性相互作用の増強も熱安定性の向上に寄与していると考えられている。
タンパク質の四次構造も変性の抑制に寄与している。例えば、リブロース1,5-ビスリン酸カルボキシラーゼ/オキシゲナーゼ(ルビスコ)の場合、古細菌のtype IIIとその他(植物などが有するtype Iおよび光合成細菌などが有するtype II)は大きく異なる。Type Iは各8つの大サブユニット[ 英: Large subunit:L ]と小サブユニット[ 英: Small subunit:S ]からなる(L2)4S8のヘテロ16量体構造で、Type IIはL2の2量体構造であるが、T. kodakarensisのType IIIルビスコ( Tk-Rubisco)は(L2)5の10量体構造である。前田はTk-Rubiscoのアミノ酸残基を変異体に変えた結果、L2構造に崩れて耐熱性が低下することを発見した
超好熱菌はゲノムDNAをリバースジャイレース[ 英: reverse gyrase ]で安定化させている。これは環状ゲノムの巻き数を増やす(正のスーパーコイルを導入する)ATP依存性DNAトポイソメラーゼであり、ゲノムDNAの二重螺旋をよりほどけにくいようにする。この酵素の発現の有無が、85度や93度といった高温環境での生育において重要である。また、リバースジャイレース遺伝子は超好熱菌一般かつ特異的に存在する。
ヒストンやポリアミンもゲノムDNAの熱安定性に寄与している。古細菌が持つヒストン様タンパク質はDNAの変性解離温度を20度以上上昇させる。スペルミンといったポリアミンはゲノムDNAのコンパクトな立体構造を維持し、高いカリウム塩濃度はDNAの解離を抑制することも明らかとなっている。
古細菌の膜脂質は、熱に強いアーキオール[ 英: archaeol ]で構成されている。ほかにも、アーキオールが2つつながった構造のカルドアーキオール[ 英: caldarchaeol ]や、カルドアーキオールにシクロペンタンが導入されたものもある。アーキオールの熱耐性は、炭水化物成分とグリセロール成分との間の結合がエーテル結合である点に由来する。真核生物や真性細菌ではエステル結合であるが、エーテル結合はエステル結合よりもより化学的に安定である。
また、好熱細菌において、細胞膜の安定性を高めるため、より低い流動性の膜脂質の割合を増やす性質が知られている。Acidilobus sulfurireducensは、培養温度が65度、70度、75度、81度、と上がっていくにつれ、カルドアーキオール中のシクロペンタンの割合を増加させる。膜脂質の主成分がアーキオールとカルドアーキオールであるT. kodakarensisは、培養温度が60度、85度、93度と上がっていくにつれ、カルドアーキオールの割合を増加させる。
代謝中間体の中には高温によって分解されやすい化合物も含まれるため、好熱菌はこれに適応した代謝経路を持つ。例えば、糖新生経路におけるジヒドロキシアセトンリン酸(DHAP)とグリセルアルデヒド3リン酸(GAP)からフルクトース6リン酸(F6P)を合成する反応は、多くの超好熱菌ではたった一つの酵素(フルクトース-1,6-ビスホスファターゼ/フルクトース-1,6-ビスリン酸アルドラーゼ[ 英: fructose-1,6-bisphosphatase/fructose-1,6-bisphosphate aldolase:FBPase V/FBPald ])によって触媒されている。この反応は、熱で分解されやすいフルクトース-1,6-リン酸(FBP)を中間体としている。超好熱菌は1つの酵素上でだけで触媒することで、基質から産生したFBPをすぐに消費することを可能にしている。そうすることで、FBPが高温に被曝する時間を短縮している。これに対して、好熱菌以外の生物では1番目の酵素フルクトース-1,6-ビスホスファターゼ(FBPase)が2つの基質からFBPを合成した後に2番目の酵素フルクトース-1,6-ビスリン酸アルドラーゼ(FBPald)がF6Pを合成する。このため、FBPが基質から作られた後に解離して次の酵素に移動するまでの時間が必要となる。
熱に弱い中間体を経ずに直接、目的の代謝産物を合成する例もある。一部の超好熱菌は、解糖系における3-ホスホグリセリン酸(3-PGA)の合成を、弱熱性の1,3-ビスホスホグリセリン酸(1,3-BPG)を経ずに行う(右図)。これを触媒する酵素はGAPフェレドキシンオキシドレダクターゼ[ 英: GAP ferredoxin oxidoreductase:GAPOR ]または非リン酸化型GAP脱水素酵素[ 英: non-phosphorylating GAP dehydrogenase:GAPN ]である。一般的な生物では、3-PGAの合成は1,3-BPGを中間体としてグリセルアルデヒド3リン酸デヒドロゲナーゼ(GAPDH)と3-ホスホグリセリン酸キナーゼ(PGK)によって触媒される。
低温耐性
低温における微生物のストレス耐性として一般的なのは細胞膜組成を変化させることである。これは、低温による生物への害は第一に膜中の流動性の低下であるためである。超好熱性古細菌であるMethanocaldococcus jannaschiiの場合、生育至適温度(75度)では主な膜脂質はテトラエーテル型や大環状ジエーテル型の脂質であるが、低温(47度)ではジエーテル型脂質になる。温度依存的な膜脂質の組成の変化は超好熱性古細菌Termococcus kodakarensisでも確認されている。
低温による核酸分子やタンパク質の構造の異常変化(変性)への対処はシャペロンによって行われる。シャペロンは、変性した構造を元の状態に戻す働きを持つ。低温下での変性とは、核酸の場合、分子内に熱力学的に安定な二次構造が形成されて転写と翻訳の過程に問題が生じることである。タンパク質の場合、構造変化は機能を喪失させる。
低温に対応するRNA結合性シャペロンの一群を低温ショックタンパク質[ 英: cold-shock protein:Csp ](RNAシャペロン[ 英: RNA chaperone ])と呼ぶが、Csp遺伝子は好熱性細菌であるThermus thermophilusやThermotoga maritimaも持っている。Cspは、RNA上に生じた余分な二次構造を一本鎖状にほどき、遺伝子発現とタンパク質合成を可能にする。Cspには低温応答性[ 英: cold-induced ]のものと非低温応答性[ 英: non-cold-induced ]のものがある。大腸菌の場合、Csp遺伝子は9種類あるが、そのうち4つが低温応答性である。
低温に対応するタンパク質結合性分子シャペロンの例として、T. kodakarensisにてCpkAが発見されている。CpkAは低温依存的に発現し、低温で変性したタンパク質を特異的に認識して再生させる。CpkAが低温への適応にどれほど重要なのかを示す研究結果が2015年に示された。それは、CpkAのATPase活性(変性状態から天然状態に回復させるためのエネルギーをシャペロンが作るための活性)の至適温度をさらに低くする点変異を導入したT. kodakarensisが、より低い温度でも生育したというものである。
RNAの低温変性に対しては、シャペロンのほか、ある種のRNAヘリカーゼも対処する。T. kodakarensisは低温ストレス応答性DEADボックスRNAへリカーゼ[ 英: cold stress-inducible DEAD box RNA helicase:Tk-DeaD ]を持つ。これは60度で機能し、ステム構造のRNAをほどく反応[ 英: unwinding ]を触媒する。Tk-DeaD遺伝子の破壊株は60度で増殖後に溶菌することからこの温度帯の生育に必須であることが示唆されている。
Tk-DeaDの研究は、好熱菌において低温応答性遺伝子はどのようにして低温をトリガーに発現誘導されるか、その機構の一つの解明につながった。低温発現は、SD配列とTk-DeaD遺伝子の開始コドンとに挟まれたアデニン連続領域(AAAAA配列)によって誘導されている。RNAポリメラーゼがアデニンを転写するとチミンが合成され、鋳型鎖上のアデニンと娘鎖上のチミンは水素結合するが、重要なのはこの水素結合は弱いという点である。したがって、AAAAA配列は鋳型鎖と娘鎖との間に、高温に対しても特に弱い結合部位を作り出す。温度が高くなればなるほど鋳型鎖と娘鎖の結合は切れやすくなり、転写が終了する確率が高くなる。おそらく生育至適温度(85度)ではAAAAA配列を超えて転写されることは不可能であろう。このため、AAAAA配列より下流にあるTk-DeaD遺伝子は低温でなければ転写されなくなる。
Tk-DeaD遺伝子で見られたような、弱い水素結合を生み出す塩基配列による低温発現誘導機構はT. kodakarensisに多く存在する。生育至適温度(85度)に比べて低温(60度)で、T. kodakarensisの50遺伝子で4倍以上の発現量の増加が見られた。このうち40遺伝子でAまたはTに富む配列がSD配列と開始コドンの中間領域に認められた。
進化との関連
超好熱菌の高温/低温耐性の研究は、生物の進化の過程を解き明かすための手段として有用であるとされている。なぜなら、超好熱菌は原始生命体に近いと推測されており、また、超好熱かつ嫌気的環境は生命誕生当初の地球に似ていると予測されているためである。すなわち、超好熱菌の高温耐性は原始生命体のそれと近いと考えられている。また、超好熱生物から常温生物への進化、すなわち高温環境からより低温の環境への進出の過程で高温耐性の退化と低温耐性の発展が起こったと考えられている。
この取捨選択の歴史についてのいくつかの示唆が、超好熱菌の研究から与えられている。まず、高温耐性の退化は、酵素においては常温での反応回転数を高めるために実行されたと考えられている。一般に、耐熱性の高い酵素は常温では常温菌由来の酵素よりも活性が低い。これはタンパク質の耐熱性が反応回転数を抑制しているためとされている。常温環境への進出に伴い、その環境でより活性の高い酵素が選択された結果、耐熱性が失われたと考えられる。
好熱菌の低温誘導型シャペロニンCpkAの獲得が、生物の常温での繁栄に重要だったと考えられている。CpkAは、真性細菌の持つ高温誘導型シャペロニンのGroELとの類似点を多く持つ。例えば、両者ともTIM(β/α)8バレルドメインを持つタンパク質を優先的に捕捉し、かつ、特徴的なグリシン-メチオニンモチーフを有する。
歴史
1960年代 陸上の温泉(イエローストーン国立公園、日本では箱根、伊豆など)から菌を分離。生育限界温度80°C以上の微生物が発見され始める。
1970年代 潜水艇アルビン号により深海熱水鉱床が発見され、熱水噴出孔に微生物が存在することを示唆。
1980年代 至適生育温度が100°C以上の微生物が多く発見される。生育限界温度は1980年には87°C (Sulfolobus solfataricus) であったが、1983年にはPyrodictium occultumが発見され、一気に110°Cに達した。
1993年 キャリー・マリスが耐熱性DNAポリメラーゼを用いたPCRの研究によりノーベル化学賞を受賞する。このとき用いられたDNAポリメラーゼは好熱菌 (Thermus aquaticus) のものであり、Taqポリメラーゼの名前はここに由来する。
- 限界生育温度更新の歴史
- 1920年 - 65℃Geobacillus stearothermophilus
- 1969年 - 80℃Thermus aquaticus(以下全種熱水系)
- 1972年 - 85℃Sulfolobus acidocaldarius(以下全種古細菌)
- 1980年 - 87℃Sulfolobus solfataricus
- 1981年 - 97℃Methanothermus fervidus(以下海洋の熱水噴出孔)
- 1981年 - 110℃Pyrodictium occultum
- 1997年 - 113℃Pyrolobus fumarii
- 2003年 - 121℃Strain 121
- 2008年 - 122℃Methanopyrus kandleri
主な好熱菌
左が限界生育温度、括弧内は至適生育温度
- 古細菌
- 122°C(105°C) - Methanopyrus kandleri Strain 116(ユーリ古細菌)
- 121°C(106°C) - “Geogemma barossii” Strain 121(クレン古細菌)記録及び命名は暫定
- 113°C(106°C) - Pyrolobus fumarii(クレン古細菌)微好気性
- 112°C(105°C) - Pyrococcus kukulkanii(ユーリ古細菌)
- 110°C(105°C) - Pyrodictium occultum、P. abyssi、P. brockiiなど(クレン古細菌)
- 108°C(106°C) - Hyperthermus butylicus(クレン古細菌)
- 108°C(98°C) - Pyrococcus yayanosii(ユーリ古細菌)
- 105°C(103°C) - Pyrococcus woesei(ユーリ古細菌)
- 104°C(102°C) - Pyrobaculum organotrophum(クレン古細菌)
- 104°C(100°C) - Pyrobaculum aerophilum(クレン古細菌)通性好気性
- 103°C(100°C) - Pyrococcus furiosus(ユーリ古細菌)
- 102°C(100°C) - Pyrobaculum islandicum (クレン古細菌)
その他Thermococcus(全27種)など超好熱菌だけで約70種。偏性好気性生物ではAeropyrum pernix(最高100°C、至適95°C。クレン古細菌)が最高。
- 細菌
- 95°C(85°C) - Aquifex pyrophilus(アクウィフェクス)好気性
- 90°C(80°C) - Thermotoga maritima(テルモトガ門)
- 85°C(70°C) - Thermodesulfobacterium commune(サーモデスルフォバクテリウム)
- 82°C(65°C) - Thermus thermophilus(デイノコックス・テルムス門)好気性
- 80°C(72°C) - Thermus aquaticus(デイノコックス・テルムス門)好気性
- 65°C(60°C) - Geobacillus stearothermophilus(フィルミクテス)好気性
超好熱菌は正式に発表されているものは2属。好熱菌は極めて多数。
- 真核生物
- 60°C(50°C) - Thermomyces lanuginosus(子嚢菌)
- 57°C(45°C) - イデユコゴメ(紅藻)
脚注
外部リンク
- 最も原始的な細菌発見 生命の起源に迫る「生きた化石」 - SankeiBiz 2012年1月18日 - ウェイバックマシン(2012年3月6日アーカイブ分)